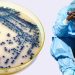
ABD uyarı yayınladı: Hızla yayılıyor! Ünlü dizi ile korkutan benzerlik…

ABD’de gündem eski lider Donald Trump
Trump Stormy Daniels’e yapılan 130 bin dolarlık sus payı Escort Kurtköy ödemesiyle ilgili soruşturuluyor
ABD’de bir hatası örtbas etmeye çalışmak o kabahatin niteliği ne olursa olsun daha önemli bir suçlamaya evrilebiliyor
Trump şayet tutuklanırsa bir kabahatle itham edilen birinci eski ABD Kurtköy Escort lideri olacak Salı günü tutuklanacağını tez eden Trump takipçilerini protestoya çağırmış ve hakkındaki tezleri reddetmişti
Manhattan savcısının ‘yozlaşmış ve son derece politik’ olduğunu tez eden eski ABD lideri protesto davetinin Kurtköy Escort Bayan de ‘ulusu geri almak’ için olduğunu öne sürmüştü
POLİS TEŞKİLATLARI ALARMA
Trump’ın işaret ettiği gün geldi çattı Trump’ın daveti nedeniyle ülkedeki büyük kentlerde polis adeta alarma geçti
New York ta polis teşkilatı içindeki tüm memurlara dedektifler dahil olmak üzere üniforma giyilmesi talimatı verildi
Washington ve Los Angeles ta da yetkililer bu olasılığa karşı vazifedeki kolluk kuvveti sayısını artırıyor
Eski bir ABD liderinin tutuklanması mümkünlüğü ile New York taki Manhattan bölgesinde güvenlik en üst düzeye çıkarıldı
Mahkeme binası önüne çelik barikatlar çekildi Çok sayıda medya mensubu da buraya kamp kurmuş durumda
MAHKEMEDEN TRUMP’A MAKÛS HABER GELDİ
ABD Trump protestolarına hazırlanırken mahkemeden eski liderin canını sıkacak bir karar geldi
Davada birtakım şahitlerin söz vermesini engellemek isteyen Trump cephesi bu çabayı kaybetti
AP’nin haberine nazaran Yargıç Lewis A Kaplan kilit şahitlerin söz vermesine müsaade verileceğine karar verdi
Amerikalı müellif E Jean Carroll’ün Trump’a açtığı tecavüz davasının 25 Nisan’da başlaması planlanıyor Carroll ve Trump’ın söz vermesi bekleniyor
Carroll 1995’te New York’ta lüks bir mağazanın soyunma odasında Trump’ın cinsel saldırısına maruz kaldığını tez ediyor
Elle mecmuasının eski köşe muharrirlerinden Carroll tecavüz davasını New York eyaletinde yürürlüğe giren yeni bir yasa kapsamında açmıştı
Yeni yasa eyalette tecavüze uğrayanlara olayın üzerinden ne kadar müddet geçerse geçsin dava açma imkanı veriyor
Trump ise Carroll’ın kendisine yönelik olarak birinci defa 2019’da lisana getirdiği tecavüz suçlamasını reddediyor